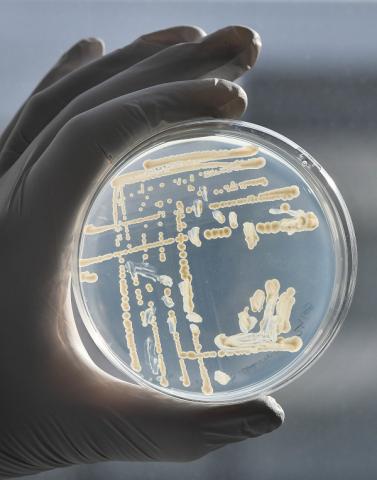

Les formations
AgroParisTech
L’offre d’enseignement d’AgroParisTech est structurée autour de quatre ensembles : le cursus ingénieur, le diplôme de master dans les domaines des sciences et industries du vivant et de l’environnement, le doctorat et une offre de formation continue dite Executive.
L’offre d’enseignement d’AgroParisTech est structurée autour de quatre ensembles : le cursus ingénieur, le diplôme de master dans les domaines des sciences et industries du vivant et de l’environnement, le doctorat et une offre de formation continue dite Executive.
La recherche
AgroParisTech
La recherche est une des missions principales d’AgroParisTech. Elle produit des connaissances scientifiques et techniques, elle alimente les formations de l’établissement, elle nourrit le dialogue sciences-société et elle est source d’innovations.
Découvrir AgroParisTech
Nous participons à la préservation du vivant en formant des citoyens engagés capables d’innover et d’agir face à l’incertitude pour former un avenir soutenable.
8 sites
cinq campus,
un centre,
une ferme expérimentale
et une antenne
3000
étudiants dont 12% de doctorants
250
enseignants-chercheurs, enseignants et cadres scientifiques
200
accords internationaux dans 54 pays

Accès directs
Rattachement
Partenariats académiques
AgroParisTech est une grande école du Ministère de l’Agriculture, de la Souveraineté alimentaire et de la Forêt, composante de l’Université Paris-Saclay. Elle développe une stratégie d’alliances au niveau territorial par le biais de partenariats avec les universités locales et leurs initiatives d’excellence.
AgroParisTech est par ailleurs membre de ParisTech et d’Agreenium.
AgroParisTech est une grande école du Ministère de l’Agriculture, de la Souveraineté alimentaire et de la Forêt, composante de l’Université Paris-Saclay. Elle développe une stratégie d’alliances au niveau territorial par le biais de partenariats avec les universités locales et leurs initiatives d’excellence.
AgroParisTech est par ailleurs membre de ParisTech et d’Agreenium.